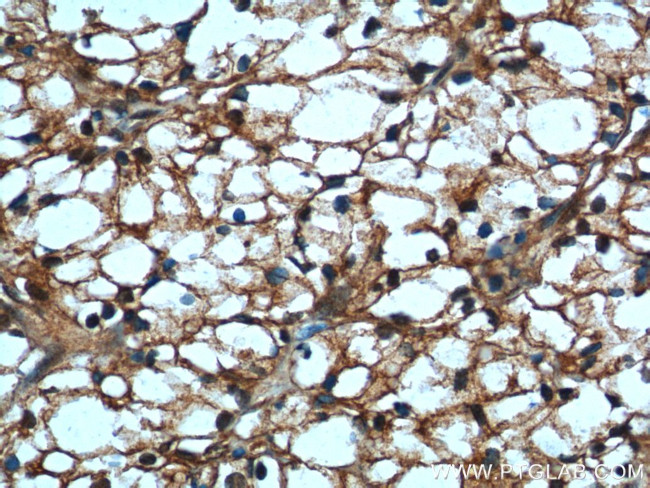
USP46 Antibody in Immunohistochemistry (Paraffin) (IHC (P))
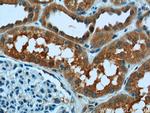
USP46 Antibody in Immunohistochemistry (Paraffin) (IHC (P))

Search
Proteintech
USP46 Polyclonal Antibody
{{$productOrderCtrl.translations['antibody.pdp.commerceCard.promotion.promotions']}}
{{$productOrderCtrl.translations['antibody.pdp.commerceCard.promotion.viewpromo']}}
{{$productOrderCtrl.translations['antibody.pdp.commerceCard.promotion.promocode']}}: {{promo.promoCode}} {{promo.promoTitle}} {{promo.promoDescription}}. {{$productOrderCtrl.translations['antibody.pdp.commerceCard.promotion.learnmore']}}
产品信息
13502-1-AP
种属反应
已发表种属
宿主/亚型
分类
类型
抗原
偶联物
形式
浓度
规格
纯化类型
保存液
内含物
保存条件
运输条件
产品详细信息
Immunogen sequence: MTVRNIASI CNMGTNASAL EKDIGPEQFP INEHYFGLVN FGNTCYCNSV LQALYFCRPF RENVLAYKAQ QKKKENLLTC LADLFHSIAT QKKKVGVIPP KKFISRLRKE NDLFDNYMQQ DAHEFLNYLL NTIADILQEE KKQEKQNGKL KNGNMNEPAE NNKPELTWVH EIFQGTLTNE TRCLNCETVS SKDEDFLDLS VDVEQNTSIT HCLRDFSNTE TLCSEQKYYC ETCCSKQEAQ KRMRVKKLPM ILALHLKRFK YMEQLHRYTK LSYRVVFPLE LRLFNTSSDA VNLDRMYDLV AVVVHCGSGP NRGHYITIVK SHGFWLLFDD DIVEKIDAQA IEEFYGLTSD ISKNSESGYI LFYQSRE (1-366 aa encoded by BC037574)
靶标信息
Modification of cellular proteins by ubiquitin is an essential regulatory mechanism controlled by the coordinated action of multiple ubiquitin-conjugating and deubiquitinating enzymes. USP46 belongs to a large family of cysteine proteases that function as deubiquitinating enzymes.
仅用于科研。不用于诊断过程。未经明确授权不得转售。
生物信息学
蛋白别名: Deubiquitinating enzyme 46; Ubiquitin carboxyl-terminal hydrolase 46; ubiquitin specific protease 46; Ubiquitin thioesterase 46; ubiquitin thiolesterase 46; Ubiquitin-specific-processing protease 46; unnamed protein product
基因别名: 1190009E20Rik; 2410018I08Rik; AI451644; RGD1564808; USP46
UniProt ID: (Human) P62068, (Rat) F1M625, (Mouse) P62069
Entrez Gene ID: (Human) 64854, (Rat) 289584, (Mouse) 69727